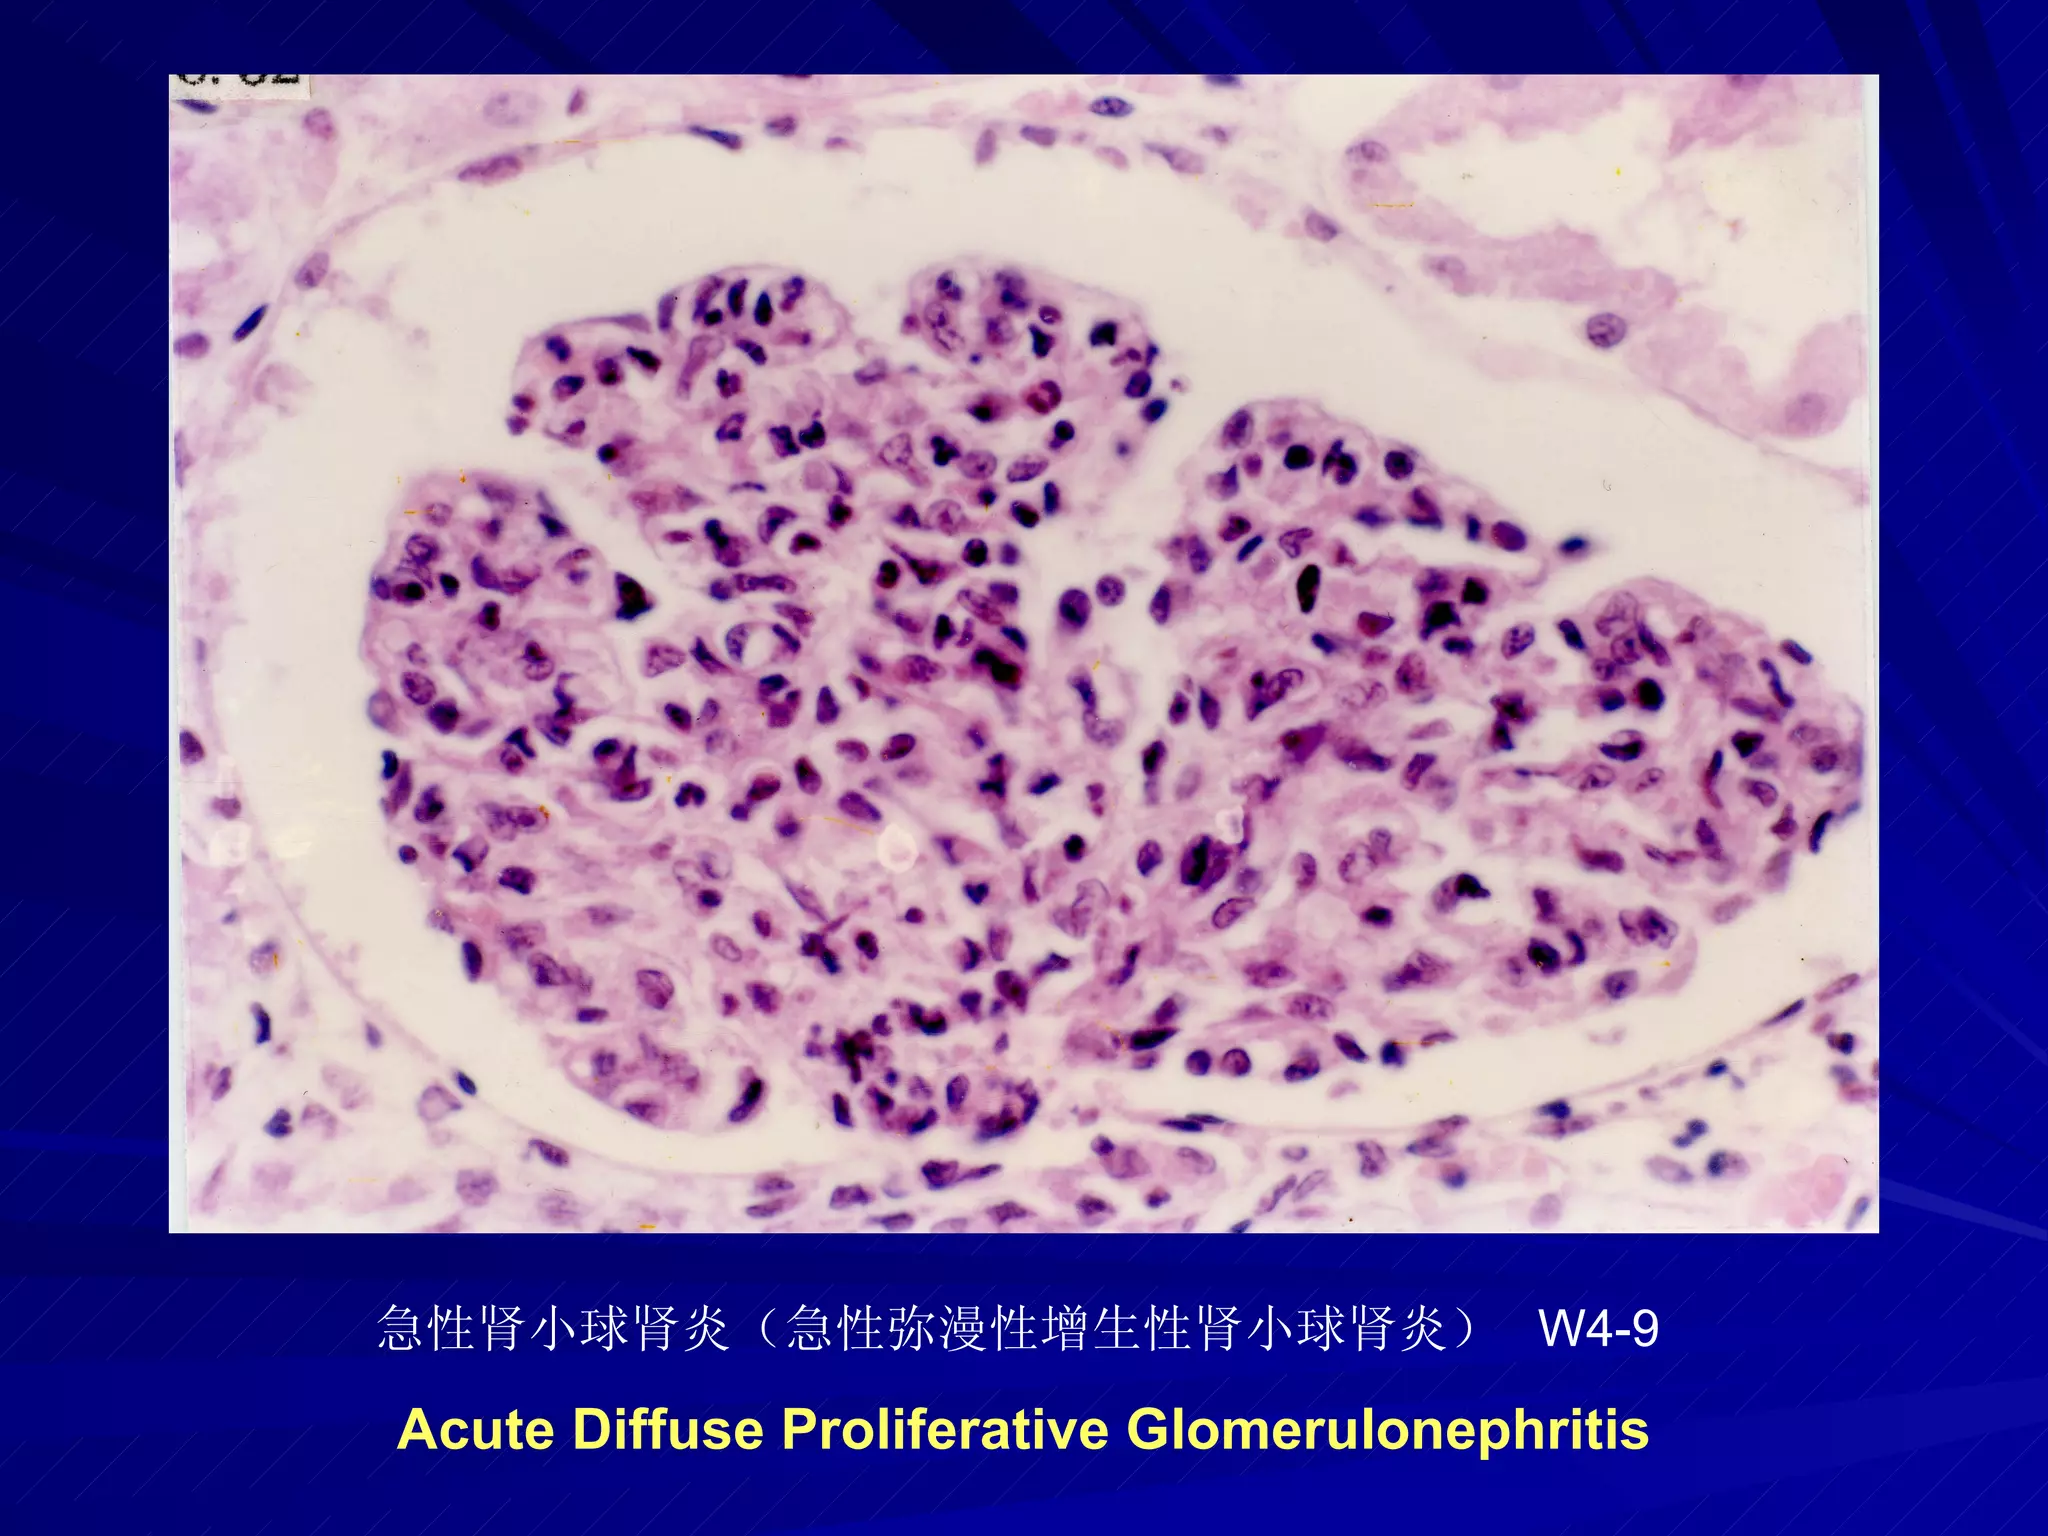
pathology practical original slide NO4
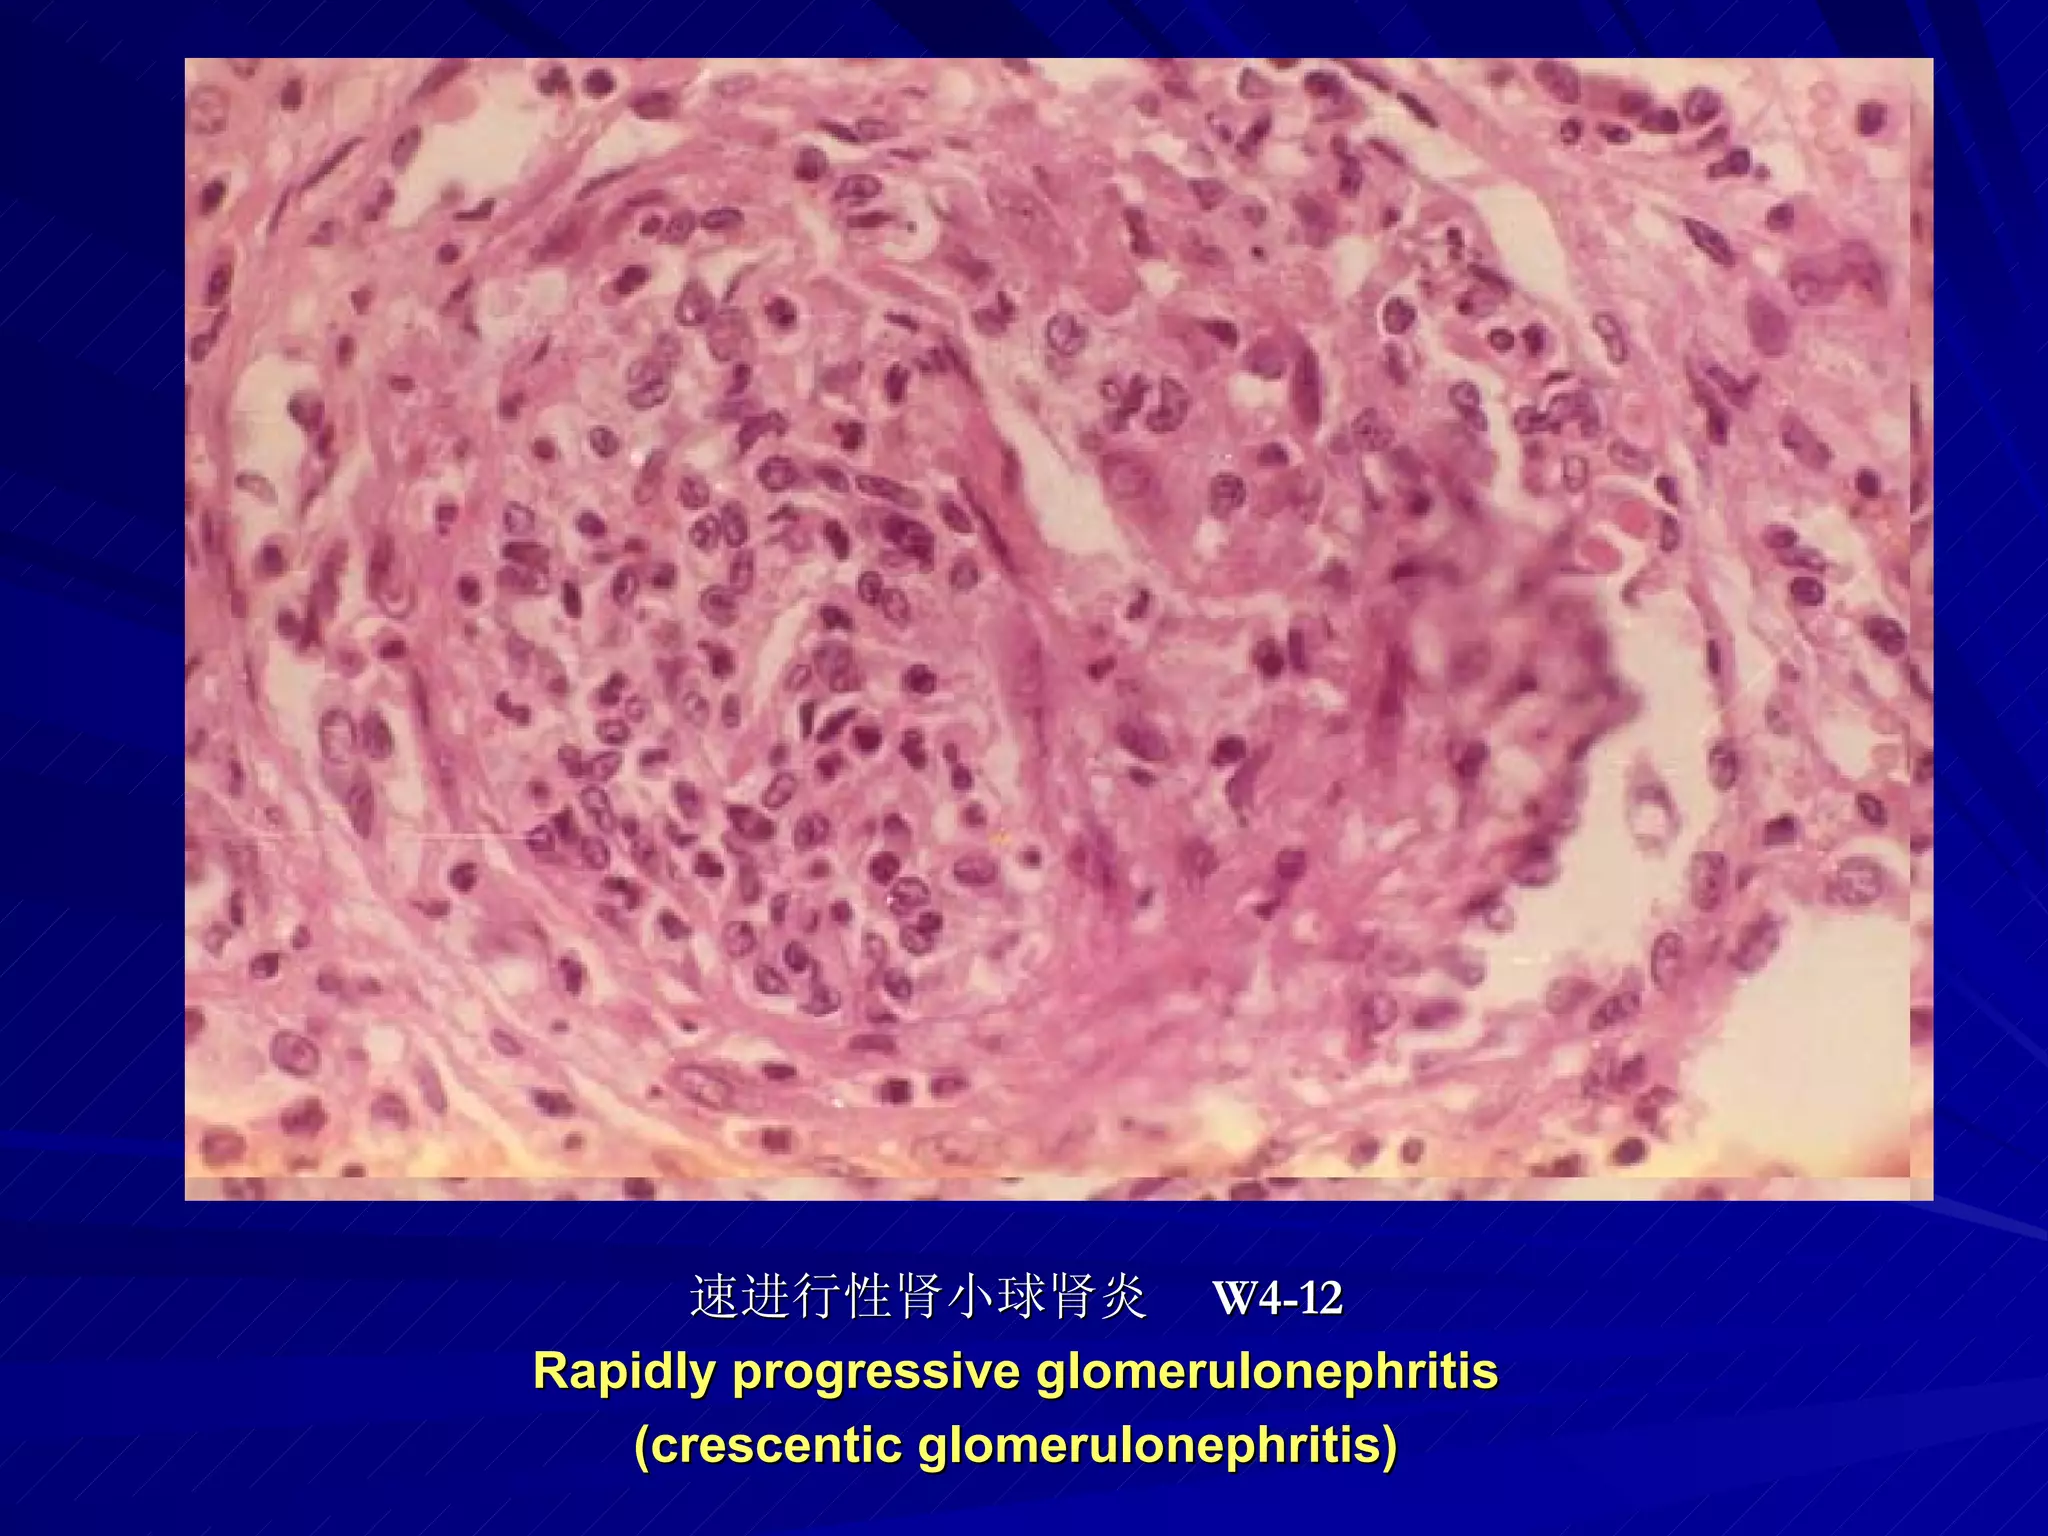
pathology practical original slide NO4

Embed presentation
Downloaded 24 times















This document contains a list of medical terms and corresponding codes. Some of the terms listed include myocardial infarction, gastric ulcers, liver cirrhosis in various types (micronodular, portal, macronodular, postnecrotic), acute diffuse proliferative glomerulonephritis, and rapidly progressive glomerulonephritis. Each term is associated with a code beginning with W4 that is intended to classify or catalog the medical condition.